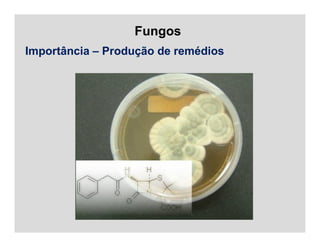
Fungos
Importância – Produção de remédios

O documento discute microrganismos eucarióticos como fungos, protozoários e nematóides. Apresenta as principais características dos fungos, incluindo que são eucariotos com parede celular de quitina, reprodução assexuada e sexuada, e importância como agentes patogênicos de plantas e na produção de alimentos e remédios. Também discute brevemente a classificação, morfologia, locomoção, nutrição e reprodução de protozoários.